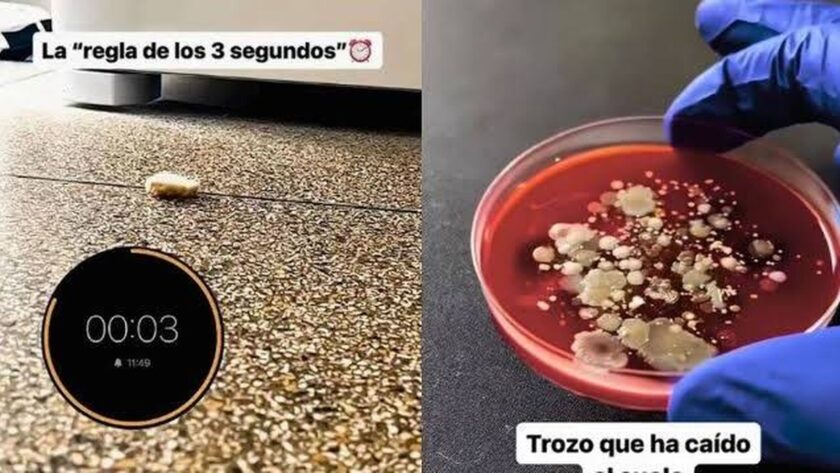

Mýtus tří sekund: Co skutečně znamená poté, co jídlo spadne na zem
Teresa Arnandis, biochemička a známá osobnost v oblasti vědeckého zpravodajství na sociálních sítích, nedávno zbořila jedna z nejčastěji šířených mylných představ o hygieně potravin – takzvanou „pravidlo tří sekund“. V nedávném videu, které sdílela, předvádí experiment, který dokazuje, že i když jídlo zvedneme ze země okamžitě, nedochází tím k vyloučení bakteriální kontaminace, a to ani po případném vyfoukání.
Arnandis vysvětlila, že cílem experimentu bylo ověřit, zda má „pravidlo tří sekund“ nějaký reálný základ. K tomu podrobně popsala, jak test prováděla: „Vezme jídlo, které bylo v kontaktu se zemí, a umístí ho na Petriho misku s agarem. Stejně tak vzala kus jídla, který nespadl na zem.“
Jednoduchý experiment s přesvědčivými výsledky
Po inkubaci obou vzorků při 37 stupních Arnandis ukazuje výsledky: „Můžeme vidět, že na kusu, který spadl, se vytvořila velká řada bakteriálních kolonií, zatímco kus, který nespadl, má jen minimální bakteriální kontaminaci.“ Fotografie jasně ukazují rozdíl mezi oběma miskami, což potvrzuje, že kontaminace se děje okamžitě.
Biochemička tímto empiricky vyvrací rozšířenou víru o bezpečnosti potravin, které spadly na zem. „Nyní víte, že to, co spadne na zem, se nesmí jíst,“ uzavírá Arnandis ve videu, čímž zdůrazňuje význam uplatňování vědeckých kritérií i v každodenních drobných gestech.
Kontakt se znečištěnými povrchy způsobuje okamžité přenášení bakterií, zejména v humidních prostředích nebo na površích s organickými zbytky. Různé studie v mikrobiologii ukázaly, že faktory jako typ země, vlhkost a složení potravin ovlivňují množství přenesených mikroorganismů, ale nikdy zcela neodstraní riziko. Závěr Arnandis je jasný: rychlost nechrání před kontaminací a „pravidlo tří sekund“ je mýtus bez vědeckého podkladu.